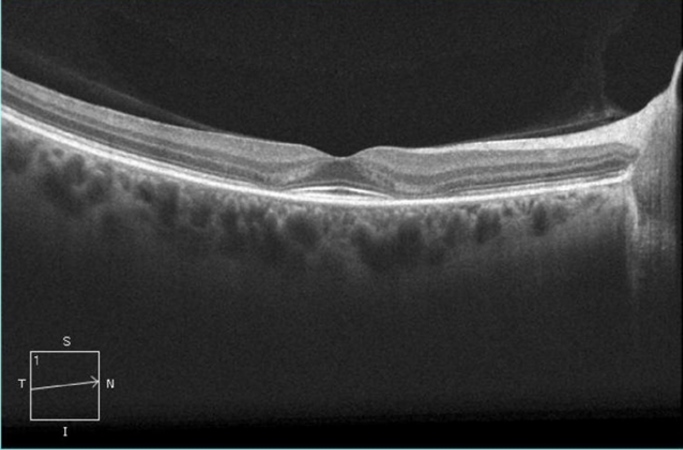

La toxicidad retiniana por cloroquina y su anánologo hidroxicloroquina es conocida desde hace muchos años. Actualmente la hidroxicloroquina es ampliamente usada para el tratamiento del lupus eritematoso sistémico, artritis reumatoide, así como en algunas condiciones dermatológicas relacionadas a procesos inflamatorios.
En una publicación reciente de la revista Ophthalmology se resumen los principales factores de riesgo así como las recomendaciones de cribado para evitar toxicidad retiniana por la academia americana de oftalmología.
El mecanismo por el cual se produce toxicidad retiniana aún no está bien entendido, sin embargo se han reconocido efectos en el metabolismo de las células de la retina. La cloroquina e hidroxicloroquina se unen a la melanina en el epitelio pigmentario de la retina (EPR) y podría permitir una alta concentración de estos agentes y por lo tanto contribuir a los efectos tóxicos.

La imagen clínica característica clásicamente ha sido una maculopatía bilateral en “ojo de buey” una apariencia causada por un anillo parafoveal de despigmentación del EPR que excluye la zona foveal central. De cualquier forma este patrón ya no debería ser visto, ya que las recomendaciones actuales podrían detectar toxicidad antes de un daño visible en el examen del fondo de ojo, el cual es irreversible.
Los principales factores de riesgo para desarrollar retinopatía son el uso de altas dosis así como un largo tiempo de duración. Una publicación reciente demostró que el riesgo es altamente dependiente de la dosis diaria por peso. Esta información muestra que el peso real del paciente fue mejor indicador que el peso ideal del paciente para calcular la dosis, por lo que el mas bajo riesgo se consigue en dosis < 5 mg/kg de peso real.
Es recomendable una valoración oftalmológica al inicio de la terapia con cloroquina o hidroxicloroquina, para excluir cualquier alteración preexistente en el área macular. Con dosis apropiadas y en ausencia de factores de riesgo, el cribado podría ser diferido hasta completar 5 años de exposición. Sin embargo se considera que la exploración anual es suficiente ya que la toxicidad se desarrolla muy lentamente. Las exploraciones más frecuentes podrían ser consideradas para pacientes con mayores factores de riesgo.
Se recomienda el uso de campos visuales automatizados y la OCT de dominio espectral, para el cribado rutinario primario ya que estos están ampliamente disponibles. Los campos visuales son altamente sensibles y confiables, el patrón de campo 10-2 tiene una alta resolución dentro de la macula. La OCT de dominio espectral muestra un adelgazamiento de las capas de los fotorreceptores en las regiones parafoveales. Estos adelgazamientos son fuertes indicadores de toxicidad. Otro estudio que puede ser de gran utilidad en casos sospechosos es el electrorretinograma multifocal, el cual genera una respuesta topográfica a través del polo posterior y puede objetivamente documentar una depresión parafoveal en la retinopatía temprana.Actualmente no se recomienda para el cribado la exploración exclusiva de fondo de ojo, angiografía con fluoresceína, el electrorretinograma de campo amplio, rejilla de Amsler, el test de colores.
Si tienes alguna pregunta, duda o comentario puedes escribirnos en nuestro muro de facebook:
Bibliografía:
1.- Michael F. Marmor, MD, Ulrich Kellner, MD, Timothy Y.Y. Lai, MD, FRCOphth, Ronald B. Melles, MD, William F. Mieler, MD,Recommendations on Screening for
Chloroquine and Hydroxychloroquine Retinopathy (2016 Revision), Ophthalmology 2016;123:1386-1394.